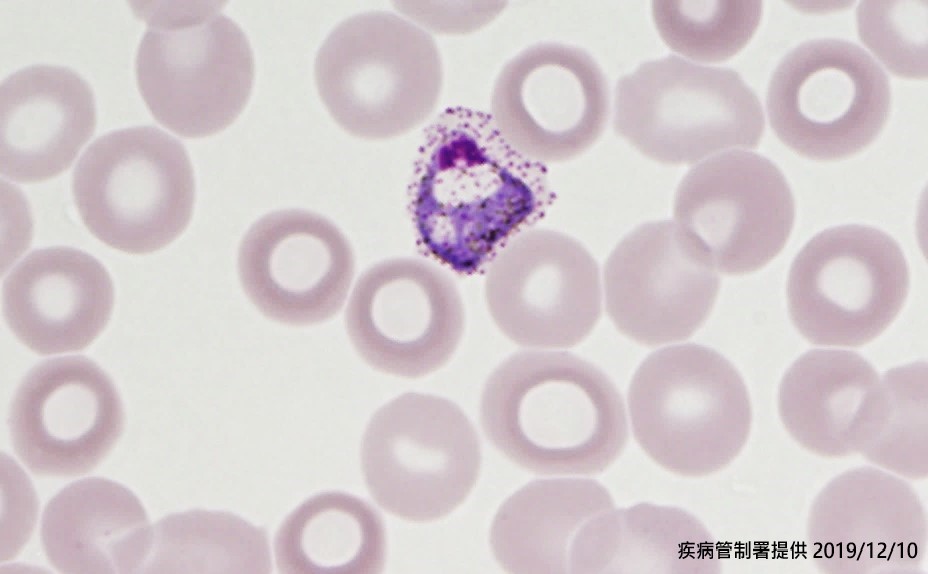

疾病管制署公布國內新增1例境外移入瘧疾病例,為南部50多歲本國籍女性,8月上旬至10月下旬曾至非洲衣索比亞工作,但未取得及服用瘧疾預防用藥,10月中旬因發燒於當地就醫,診斷疑似瘧疾收治住院4天,狀況改善後出院未再服藥;10月下旬返國入境時雖無症狀,但仍主動通報機場檢疫站在非洲當地疑似感染瘧疾,並於隔日就醫,血片鏡檢影像未發現瘧原蟲;12月6日個案出現發燒、上呼吸道感染症狀就醫,採血檢驗發現疑似瘧原蟲,經通報檢驗於昨(9)日確診感染間日瘧,研判因於非洲當地治療不完全致瘧原蟲潛伏在肝臟內伺機釋出而造成復發,為國內近三年來境外移入瘧疾復發首例,個案目前住院觀察中,衛生單位將持續追蹤至檢體檢驗結果陰性為止;個案同住家人目前無不適症狀。
今(2019)年截至12月9日共計7例瘧疾病例,均為境外移入,感染國家分別為衣索比亞2例,烏干達、奈及利亞、剛果共和國、索羅門群島及巴布亞紐幾內亞各1例;檢出病原體為間日瘧及惡性瘧(熱帶瘧)各3例,三日瘧1例。今年累計病例數低於2015-2016年同期(為9、13例),與2017-2018年相當(為7、6例);近5年個案感染地區以非洲國家為多,檢出病原體以熱帶瘧為主,其次為間日瘧。
瘧疾是由感染瘧原蟲之瘧蚊叮咬人類而傳染的疾病,可分為間日瘧、三日瘧、熱帶瘧、卵形瘧;其中以間日瘧及熱帶瘧最常見。大多數人感染後,症狀可能於7天至30天內出現,早期症狀與流感類似,主要為發燒,也可能出現頭痛、肌肉痛、關節痛、噁心、嘔吐和疲倦等症狀,如未接受適當的治療,發病數天後會出現間歇性或週期性的畏寒及顫抖、發燒及出汗等症狀,嚴重者可能導致脾腫大、黃疸、休克、肝腎衰竭、肺水腫、急性腦病變及昏迷。間日瘧跟卵形瘧可能潛伏在肝臟數星期或甚至數年後再復發,所以在治療完血液瘧原蟲之後,必須要加用primaquine服用14天做根除治療,以避免間日瘧或卵形瘧復發。
疾管署呼籲,民眾前往瘧疾流行地區,請至少於出國前一個月,先至國內旅遊醫學門診諮詢,並依醫師指示於出國前、出國期間及返國後持續不中斷服用瘧疾預防藥物;旅遊期間請盡量穿著淺色長袖長褲,塗抹政府機關核可的防蚊藥劑,並住在有紗門紗窗的房舍;返國後如出現疑似症狀應儘速就醫,並提供醫師旅遊史及曾服用的瘧疾預防藥物等資訊,以做為診斷與治療參考。相關資訊請至疾管署全球資訊網(https://www.cdc.gov.tw),或撥免付費防疫專線1922(或0800-001922)洽詢。